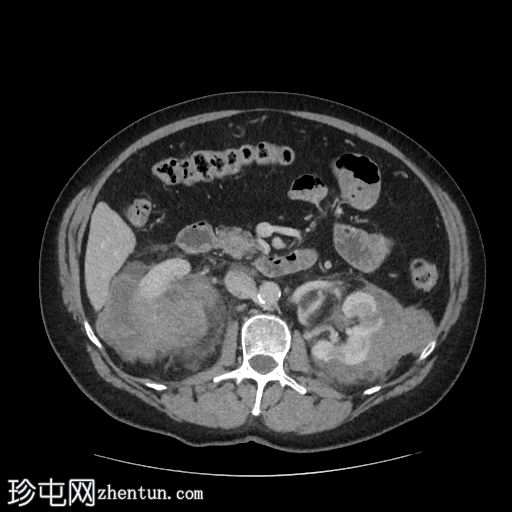
1.jpg

主诉
腹痛。
患者资料
年龄:50岁
性别:男
CT
轴位增强扫描(门静脉期)
冠状位增强扫描(门静脉期)

矢状位增强扫描(门静脉期)

右肾可见不规则分叶状低密度浸润性病变,超出肾包膜,并与右肝下叶相邻。
左肾可见弥漫性浸润性病变,以上极为中心。左肾浸润性病变与胰尾相邻,胰尾可能受累,表现为胰腺后缘不规则、脂肪间隙消失。此外,浸润性病变与左侧肾上腺外侧肢相邻。
左肾偶然发现一小结石和肾囊肿。
脾脏下极可见一密度不明、呈分叶状/浸润性改变的肿块。
胆囊内可见少量胆结石。
病例讨论
本例为肾淋巴瘤,具体为弥漫性大B细胞淋巴瘤(DLBCL)。
鉴于其浸润性病变,高度怀疑为淋巴瘤。原发性肾脏恶性肿瘤(例如肾细胞癌、肾嗜酸细胞瘤)的可能性较小。肾脏肿块活检证实为肾脏DLBCL。 |